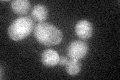
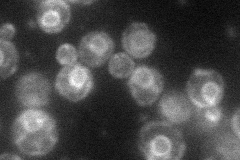
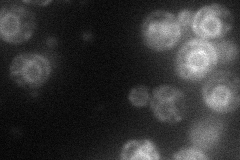
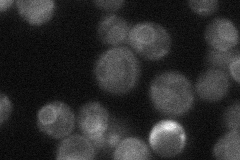
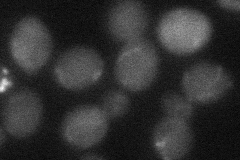

View description
Low-affinity zinc transporter of the plasma membrane; transcription is induced under low-zinc conditions by the Zap1p transcription factor
Localization:
Intensity:
Fold change:
Significance:
-
C’ GFP library in SD
ER21.44 -
N' NOP1pr-GFP in SD
ER43.7727 -
N' TEF2pr-mCherry in SD
ER31.0079 -
N' NATIVEpr-GFP in SD
ER25.8043 -
N' TEF2pr-VC and Cyto-VN in SD
below threshold25.0914 -
C’ GFP library in SD+DTT

ER16.570.77Yes -
C’ GFP library in SD+H2O2

ER16.760.78Yes -
C’ GFP library in Starvation Media

ER16.470.76Yes -
C’ GFP library on the background of Pup2-DaMP

ER -
C’ GFP library on the background of CCT mutant

ER17.48530.815059No
